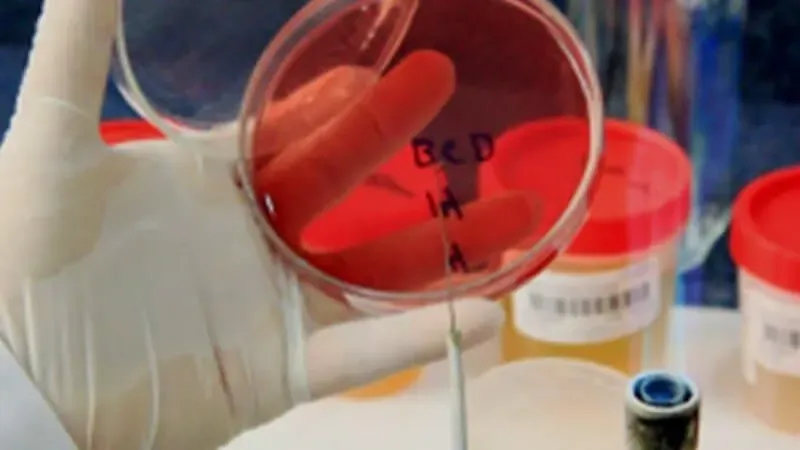
Galería en miniatura

Buscar

yext
Última actualización: 9/22/25, 5:21 PM
Información
En UNILABOR somos especialistas en realización de análisis clínicos y pruebas de laboratorio para generar diagnósticos, cuyos resultados son confiables gracias a que son hechos por profesionales altamente capacitados en Villahermosa, Tabasco.
Imágenes

Preguntas frecuentes
Que dias esta Unilabor abierto?
Abierto los Lunes, Martes, Miércoles, Jueves, Viernes, Sábado.
Que marcas trabajan con Unilabor?
UNILABOR CIDE, UNILABOR.
Cuales son los principales productos de Unilabor?
Laboratorio De Analisis Clinicos, Laboratorio E Imagenologia, Colesterol, Glucosa, Prueba De Embarazo, Hematología.
¡Atención dueños!
Registra tu comercio ahora e incrementa tu alcance global con iGlobal.
Copiado al portapapeles!